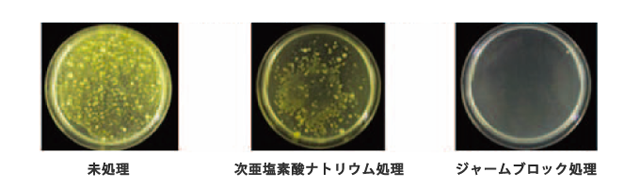

日頃より、気功整体院HANDSをご愛顧いただきまして誠にありがとうございます。
当院はこれまでお客様の心身の健康管理に携わる立場としてお客様から常に助言を求められ、お客様が心身共に最善の利益を得られるようなサービスの提供と提案をし続けるという社会的な役割を痛感しながら日々知識と技術を向上させる努力を続けて参りました。
現在、新型コロナウィルス感染症の拡大によって多くの方々が不安と恐怖を抱えて社会システムが根底から揺さぶられるまでの事態となっておりますが、当院はその最中にあっても社会的な役割を見失うことなく、お客様の心身の健康と、新型コロナウィルス感染および重症化の抑制に貢献したいと考え、当院の感染防止対策と運営方針について明示させて頂きます。
感染防止対策
お客様に安心して当院を利用して頂くために(1)スタッフの対策、(2)除菌対策、(3)ご来院に関する対策の3つの対策を取っております。
(1)スタッフの対策
- マスクの着用
- 検温と日々の体調管理(※)
※体調管理につきましては後ほど詳細に触れさせて頂きます

(2)除菌対策
除菌消毒にはGERMBLOCK(※)を導入しております。
<院内設備>
- ご予約前後の換気(室内温度に配慮しながら施術中も窓を開けています)
- GERMBLOCK噴霧による空間除菌
- 施術毎に院内の共有部分(ベッド、トイレ、蛇口、ドアノブ、手すり、スウィッチ等)を消毒

<スタッフ>
- 施術毎に流水と石鹸で手洗い
- 都度、GERMBLOCKによる手指消毒

<お客様へのお願い>
お客様におかれましてもマスクの着用と受付での手指消毒にご協力を頂いておりますので、ご理解のほど、どうぞよろしくお願い致します。
※GERMBLOCK(弱酸性次亜塩素酸水:30ppm)は岡山大学による安全性試験で人体に対する安全性が確認されており、北里研究所でも病原性細菌に対する殺菌効果と人体に対する安全性が認められており警視庁、自衛隊などの公的機関に導入されています。アルコールでも効かないウィルスや菌にも有効で有機物に触れると水に戻り飲んでも問題がないほど安全です。
弱酸性次亜塩素酸水のキュウリの除菌実験
除菌が難しいと言われているキュウリを同じ有効塩素濃度の次亜塩素酸ナトリウムとジャームブロック(弱酸性)に30分間浸漬した後の生菌測定。
次亜塩素酸水で新型コロナ不活性化「30秒以下で」
北海道大学の人獣共通感染症リサーチセンターは「次亜塩素酸水」に新型コロナウィルスの感染性を失わせる不活性化効果があることを実証しました(5/15)。
参照記事:Yahoo!ニュース

次亜塩素酸水(ph2.7以下、40ppm、室温23.5度)に新型コロナウィルス(1千万個以上)を混ぜた場合に30秒でウィルスが検出限界以下まで減少。
次亜塩素酸水の安全性について
次亜塩素酸水の濃度の基準は現在のところ定められていないため、高濃度のものを大量に吸入した場合に人体への健康被害が懸念されています。GERMBLOCK(弱酸性次亜塩素酸水:30ppm)は人体への安全性も担保されており、濃度や製法については今後の「ウィズコロナ」におけるスタンダードになるものと思われます。

(3)ご来院に関する対策
- 院内で他のお客様との施術が重なることがないようにご予約の時間をずらすように配慮しております。
- 発熱・海外渡航歴の自己申告
平熱時より1.0度以上の発熱のある方、2週間以内の海外渡航歴のある方、罹患歴がある方、体の強いだるさ、咳や痰がなかなか消えない、息苦しさがある場合は、事前に来院のご相談をお願い致します。
- キャンセル規定
新型コロナウィルスの感染予防を理由にキャンセルされる場合は通常のキャンセル規定は適用されません
運営方針
- 通常通り開院します。(2021年5月1日現在)
初回お試しコースおよび再来院ともに通常通りご予約を承っております。 - オンラインによるセルフケア講座を開催しております。
通院が困難な場合や外出をどうしても控えたいという方でも体調管理に役立てて頂けるように当院主催で「おなかのセルフケア – オンライン受講 -」を開催しております。詳細は講座ご案内サイトをご覧下さい。

当院は社会的な役割を担う立場であることを自覚して、今後も続くであろう新型コロナウィルスを含む様々なウィルスによる脅威に対してどのような対策・貢献ができるかを検討しながら、且つ、多くの人が不要な不安や恐怖を抱くことで社会的不安や麻痺に繋がることがないように情報リテラシーを高めて出来得る限り正しい情報の発信と求められる行動に努めて参ります。
特に、インターネットやメディアを通じた様々な情報が飛び交う中で信頼に足る情報に出会うことが困難な状況にあっては、本来は抱かなくて済むはずの不安や恐怖が社会全体をマイナス的な方向へと引きずり込んでいくことを危惧しております。
のみならず個々人におきましても、不要な不安や恐怖が人体の免疫機能や食物の消化吸収や精神活動に影響を及ぼすことさえあることを考えると、そうした不要な不安や恐怖を抱かずとも済む基準がどこにあるのかを提示することは急務であり責務であると考えております。
まだまだ厳しい状況が続いておりますが、お客様の精神衛生と健康を脅かす不安・症状を少しでも早く軽減できるようにこの期間も務めて参ります。もし衛生上の疑問などありましたら遠慮なくお尋ね下さい。
院長の体調管理
精神衛生上の管理
- 禅法による呼吸と精神統一の稽古を毎日続けております。それにより自己の中心や俯瞰的な視点に繋がることができ、ネガティブな感情や体験があっても瞬時にリセットして前向きな捉え方に転換することが容易になります。
- 出来うる限り肯定的な情報、会話、人物に触れるように常に意識しております。
- 定期的に自然環境の豊かな場所に足を向けるようにしております。
- 週一で空手稽古に参加し、同じく週一で劇団での演技稽古と創作活動に参加することで自己のバージョンアップに務め、同時に仲間との交流を楽しんでおります。
身体的な管理
- 空手の自主稽古を通じて身体の軸と脱力を常に意識し、筋力維持と筋力アップを心掛けております。
- 発声練習を通じて腹の底から声を出し呼吸に関連する機能と筋肉の維持に務めております。同時にストレスの発散にもなっております。
- 1~2日に1回は経絡(氣の流れ)のチェックと改善をおこない、毎晩就寝前には「お腹のセルフケア」を実施しております。就寝前にお腹の施術をすると朝の目覚めが良く4?5時間の睡眠で十分な活動ができます。その他に頭蓋仙骨システムの調整や骨盤のズレの調整などの自助を定期的におこないます。
- 朝はコップ一杯のお白湯(40度のお湯)を飲むようにして、食事については化学添加物を含む食品には常に気をつけるようにしております。水には気を遣っており、現在は素粒水を発生する浄水器を取り付けております(興味がある方はご相談下さい)。
- 毎日欠かさずに生姜と蜂蜜を入れてホット紅茶を2時間おきに飲むようにしております。紅茶にのみ含まれる2種類のポリフェノール(テアルビジンとテアフラビン)がインフルエンザウィルスを含む様々なウィルスに効果があることが医学的に証明されております。この点に関しましては代替医療の最先端技術を提供されておられるイシハラクリニックの副院長 石原新菜先生が公開されている記事をご参照下さい。「@DIME ウィルスの99.96%を無効化!インフルエンザウィルスに紅茶が効くってホント?」
なお、ミルクを入れると脂肪分がポリフェノールを吸着してポリフェノールの効果が低下するそうですのでミルクは入れません。 - 持病や投薬はありませんが7歳で鼠径ヘルニア、40歳で虫垂炎の手術を経験している事から術部の固着を起こさせないように定期的に術部にセルフ施術をしております。また、万一風邪の初期症状を感じた際にはその日のうちに体を温めて熱を出し汗をかくようにする事で翌日までには治しています(その際はお白湯を大量に飲みます)。しかし最近ではあまり風邪をひくことがありません。
以上、主な院長の体調管理法をご紹介させて頂きました。こうした日々の取り組みをしていても何らかのウィルスに感染する可能性をゼロにすることはできないかも知れません。また、気分によっては何もできないような日も実際にはありますし、そういう日が続いていると体調を崩しやすくなることも経験しております。しかし、体調管理を継続できている場合には体調を崩すことがなくなり風邪をひかなくなる経験からも、例えウィルス感染しても重症化を免れる可能性は格段にアップするだろうと考えております。
こうした日々の取り組みが自分自身の拠り所となり根拠のある自信につながりますし、何よりも、全く何もしないでただ不安や恐怖に怯えているのと比べて心理的に大きな開きが生じるものと思っております。こうした取り組みの土台があった上に感染防止対策にも取り組むことが何よりも重要だと考えております。
下の記事は院のFacebookページに掲載したものになりますが、腸の働きと脳の繋がり、外出した際の新型コロナ対策、自宅でできる体力維持法、新型コロナショックの背景に隠された本質などについて院長の考えに触れておりますのでご参考になりましたら幸いです。
Facebookページ『”フォース(愛)”があなたを軽くする』
オンライン講座のご案内
最新の医学研究では「腸」の働きが免疫機能の維持に強く関わっていることが分かってきております。当院では21年前の開業当初からお客様の「腸」やお腹全体の内臓に対するケアとセルフケアの指導をさせて頂いて参りましたが、内臓の状態が風邪の予防や他の多くの病気に密接に影響することを見出しております。
これまでは対面にて「おなかのセルフケア」を指導させて頂いておりましたが、新型コロナ感染症蔓延による外出自粛要請を受けて自宅に居ながらでも身に付けて頂けるようにシステムを構築して提供させて頂くことにしました。
どなたでも、パソコンとWi-Fi環境があればインターネットを介して対面でカウンセリングを受けて頂いて、全3回の受講を通じてお腹に対するセルフケアの技術をしっかりと身に付けて頂けるようになっておりますので、ぜひご検討下さい。
『おなかのセルフケア – オンライン受講 -』
詳細とご相談のページ
新型コロナウィルス感染症の相談について
新型コロナウィルス感染症が疑わしい場合やご相談は、下記窓口へお問い合わせ頂きますようお願い致します。
東京都 新型コロナコールセンター
電話番号:0570-550571
対応時間:9時から22時まで(土、日、休日を含む)
対応内容:感染の予防に関することや、心配な症状が出た時の対応など、新型コロナウイルス感染症に関する相談
厚生労働省の電話相談窓口
電話番号:0220-565653(フリーダイヤル)
受付時間:9時から21時まで

